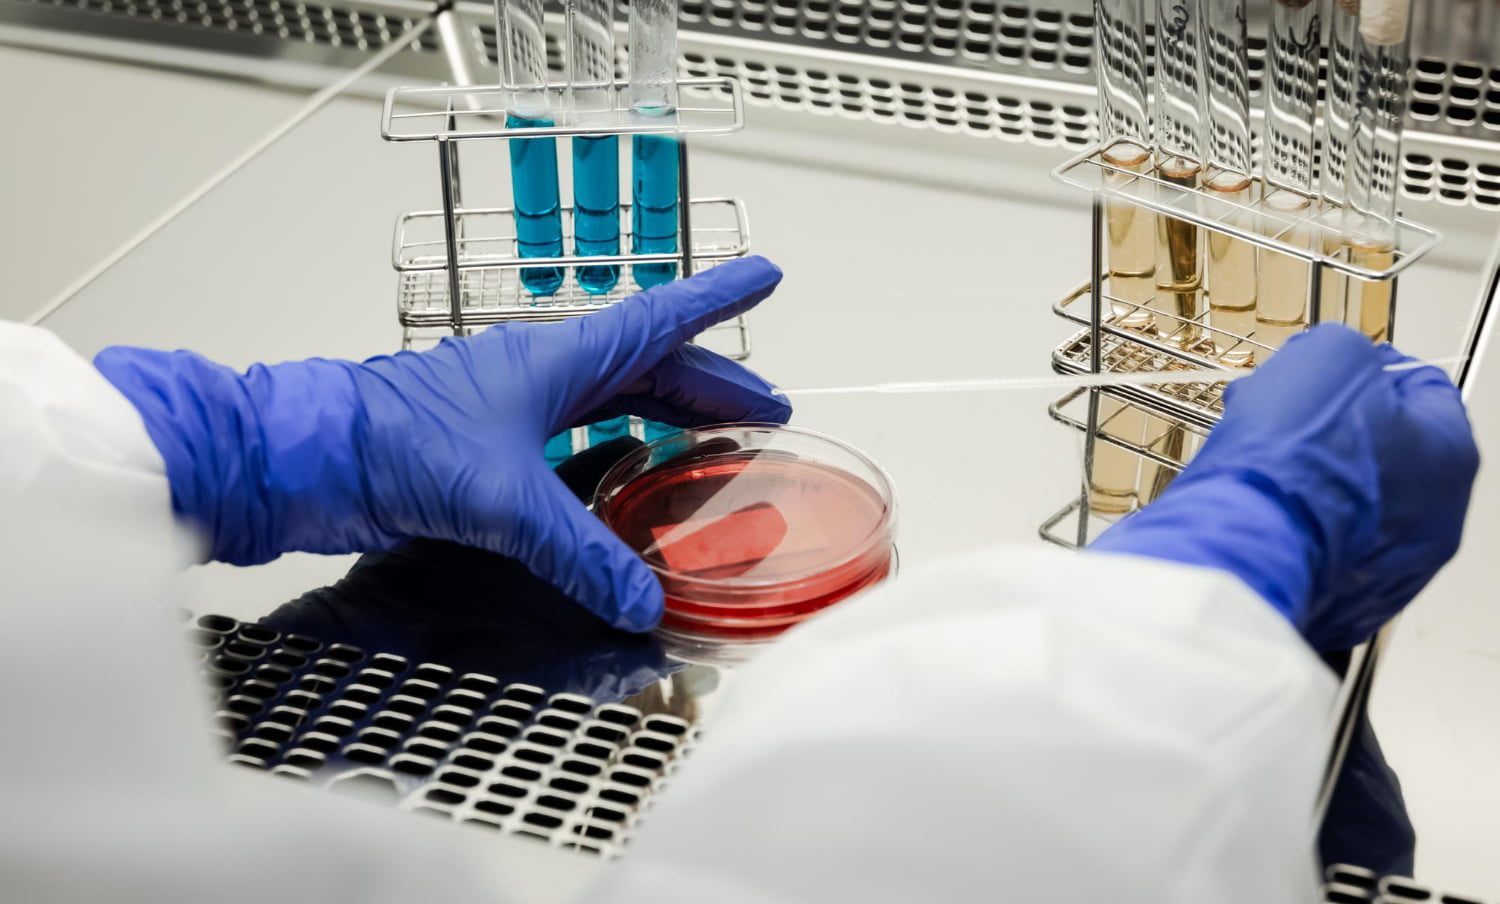

Virus, bactéries, levures: en bonne santé grâce aux microbes
Des études fascinantes parues dans les plus grandes revues savantes du monde montrent que notre matériel génétique contient des centaines de gènes hérités de micro-organismes comme les bactéries, les levures et les virus. Il y a donc une bonne part de microbes dans chacun de nous et elles sont essentielles à notre existence et notre santé.
N’en déplaise aux fondamentalistes religieux, créationnistes et autres dénigreurs du savoir scientifique, il n’y a absolument aucun doute que la vie est le résultat d’une longue évolution à partir d’organismes primitifs apparus sur Terre il y a environ quatre mil- liards d’années.
Selon les forces de la sélection naturelle imposées par les variations de l’environnement, certains de ces lointains ancêtres sont demeurés sous une forme simple, formés d’une seule cellule (bactéries, levures, protozoaires), tandis que d’autres ont graduellement évolué vers des formes plus complexes, composées d’un nombre toujours plus grand de cellules hautement spécialisées.
Cette origine commune à l’ensemble des espèces vivantes signifie que même des espèces aussi évoluées que l’être humain possèdent des caractéristiques qui sont également retrouvées chez des espèces en apparence «inférieures».
Ce concept est magnifiquement illustré par les résultats d’une étude réalisée sur la levure du boulanger (Saccharomyces cerivisiae), une forme de vie apparue au moins un milliard d’années avant nous: en remplaçant systématiquement les quelque 450 gènes essentiels à la survie de ces cellules par leurs équivalents humains, les chercheurs ont montré que dans la moitié des cas, les gènes humains permettaient aux levures de fonctionner tout à fait normalement.
Autrement dit, les avantages pour la survie conférés par ces gènes étaient tellement importants qu’ils ont été soigneusement conservés pendant un milliard d’années, de la levure jusqu’aux humains.
Au moins 145 gènes provenant de bactéries et de virus sont présents dans le génome humain
Des études récentes permettent de penser que la transmission de gènes d’espèces inférieures peut aussi se faire beaucoup plus rapidement, à l’aide d’un transfert direct entre microbes et humains.
En examinant minutieusement les génomes d’une quarantaine d’espèces microbiennes et animales, des savants ont en effet remarqué qu’au moins 145 gènes provenant de bactéries et de virus étaient présents dans le génome humain. On ne connaît pas encore les raisons de ce transfert génétique ni ses conséquences sur le fonctionnement de notre organisme, mais certaines observations laissent penser que cette étroite collaboration entre les gènes humains et microbiens pourrait dans certains cas jouer des rôles importants.
Les gènes provenant de certains virus en sont un bon exemple. On estime qu’environ 8 % de notre matériel génétique est formé d’ADN provenant de rétrovirus, une conséquence des nombreuses infections qui se sont produites au cours de l’évolution. Ces virus ne sont pas dangereux: nous nous sommes adaptés à leur présence et leur ADN s’est graduellement intégré dans notre génome et ne représente plus aucun danger pour l’organisme. Et c’est même parfois le contraire, car certains virus sont même devenus avec le temps absolument essentiels à notre existence!
Par exemple, une équipe de scientifiques américains a récemment montré qu’un virus appelé HERVK, qui s’est introduit dans les cellules de nos ancêtres il y a environ 200 000 ans, s’active au cours des premières étapes du développement pour produire une protéine qui empêche d’autres virus de pénétrer dans l’embryon, ce qui le protège du même coup d’infections qui pourraient bloquer sa croissance.
L’homme une espèce parmi tant d’autres plus simples
Il est dans la nature humaine de se considérer comme l’espèce la plus importante de la planète en raison de notre intelligence qui lui a permis de dominer le monde. Les résultats des études mentionnées plus tôt nous rappellent toutefois qu’il serait bien avisé de faire preuve d’un peu plus d’humilité et d’être moins anthropocentrique: l’être humain, malgré ses formidables capacités, demeure une espèce vivante parmi tant d’autres, dont l’existence a été rendue possible par des formes de vie beaucoup moins évoluées comme les microbes. Ces origines on ne peut plus modestes devraient donc nous rappeler que chaque espèce vivant sur la planète est apparentée, ne serait-ce qu’en partie, avec la nôtre et que nous aurions en conséquence avantage à mieux respecter notre environnement…
Sources
Kachroo AH et coll. Systematic humanization of yeast genes reveals conserved functions and genetic modularity. Science; 348:921-5.
Crisp A et coll. Expression of multiple horizontally acquired genes is a hallmark of both verte- brate and invertebrate genomes. Genome Biol, 16:50.
Grow EJ et coll. Intrinsic retroviral reactivation in human preimplantation embryos and pluripotent cells. Nature,; 522:221-5.
Cet article a été élaboré avec le soutien d’un outil d’intelligence artificielle. Il a ensuite fait l’objet d’une révision approfondie par un journaliste professionnel et un rédacteur en chef, assurant ainsi son exactitude, sa pertinence et sa conformité aux standards éditoriaux.
PRESSE SANTÉ s'efforce de transmettre la connaissance santé dans un langage accessible à tous. En AUCUN CAS, les informations données ne peuvent remplacer l'avis d'un professionnel de santé.